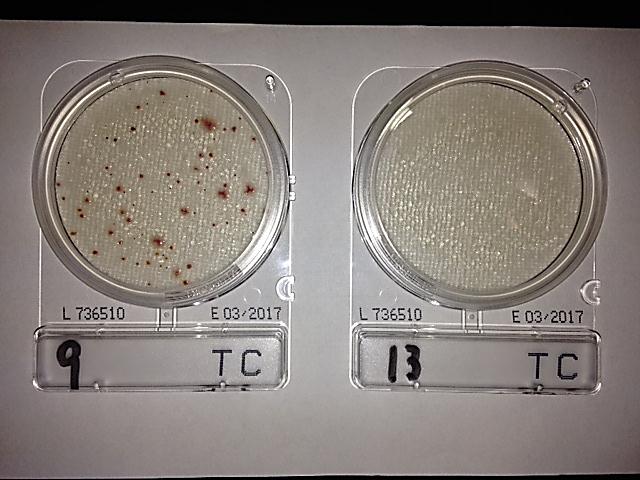

一般細菌を検査する場合は、検査する水を専用の培地に1 mL加え、人の体温に近い37℃付近で培養し、培地上で形成されたコロニー(集落)の数を計測します。
実際に、一般細菌が検出された培地を見てみましょう!
左が検出された場合、右が不検出の場合です。
専用の培地で検査を行うとコロニーは赤色に染まります。赤色に染まったコロニー1つを1個とカウントして計測を行い、「1 mL中に何個一般細菌が含まれているか」をご報告します。
一般細菌の水質基準値は水道法で、「1 mL中に100個以下であること」と定められています。そのため、1mLに100個を超えて検出されると、検査結果は「不適合」となり、飲用には適していない水となってしまいます。
例えば、200 mLサンプルを使って検査をした場合、「1 mL中に500個」という結果が出たとすると採水したサンプルの中には10万個もの一般細菌が存在することになります。
一般細菌が基準値を超えてしまう原因とは何があるのでしょうか?